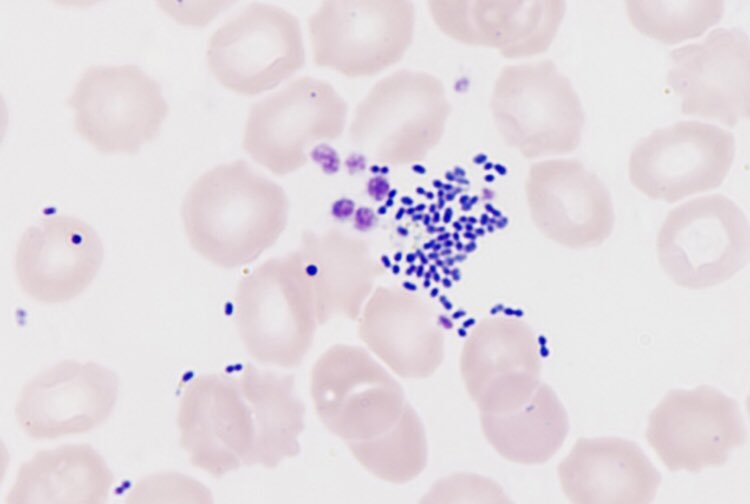

Michael McNamara
@michael_mc_n
ID: 1121481859
26-01-2013 09:29:07
94 Tweet
27 Followers
70 Following





Very rare cases of pericarditis, myocarditis are being seen after mRNA vaccines. We've seen a few here in San Diego, too. It's time to get a handle on frequency and determine the mechanism. See Suhail Allaqaband and Dr Ihsan Rafie posts, threads ECGs via Dr. Allaqaband










Happy PA week! The Irish Society of Physician Associates Heres Michael McNamara UGI intern getting into the spirit of things in St Vincent's University Hospital (SVUH) #internjobs #PAweek




This is what a kidney stone looks like under an electron microscope 🤯 Via microscopic images. #MedTwitter